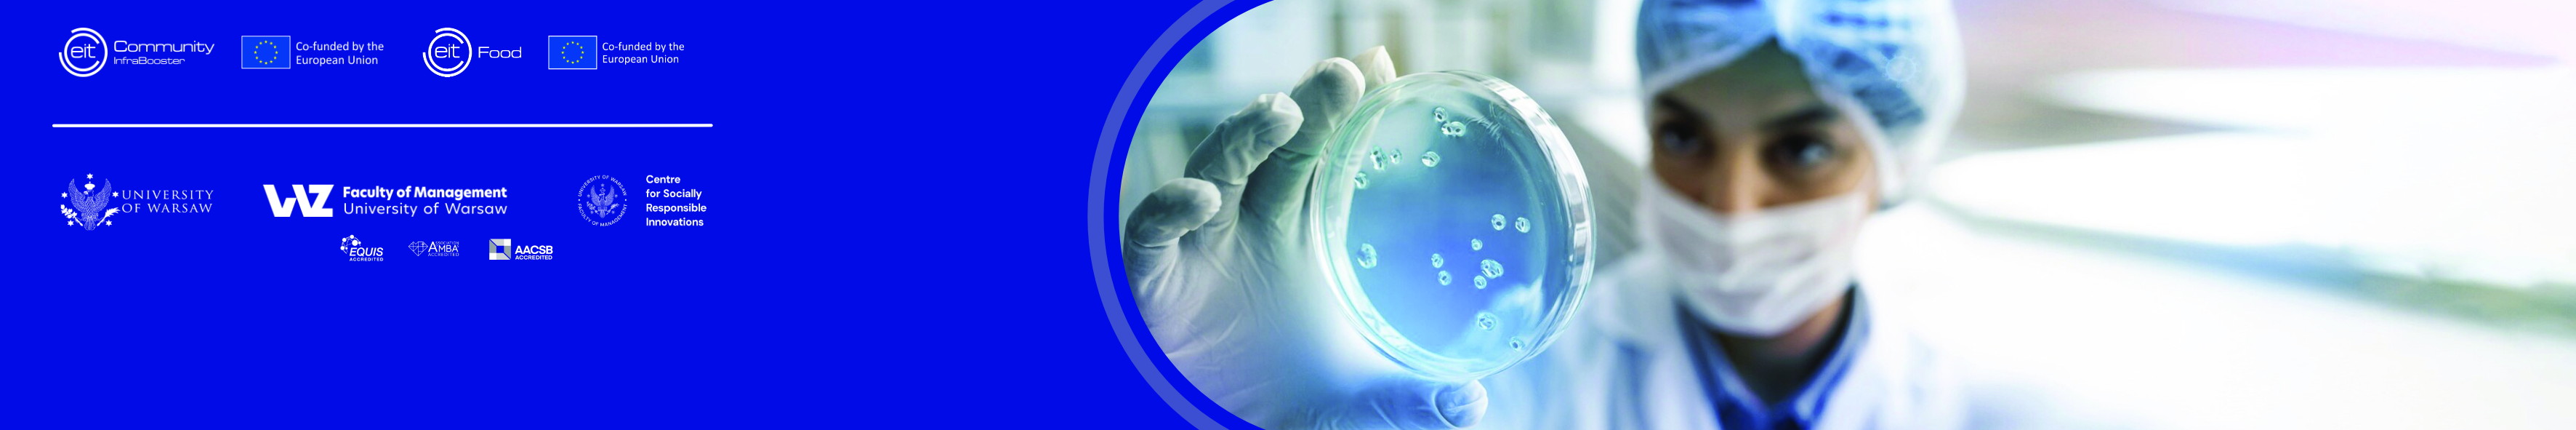

- Nauczyciel: Mansour Esmaeil Zaei
- Nauczyciel: Krzysztof Klincewicz
- Nauczyciel: Katarzyna Kotowska
- Nauczyciel: Piotr Nawrocki
Kurs nie ma daty rozpoczęcia.
Kolor tła
Czcionka
Kerning czcionki
Rozmiar czcionki
Kolory o wysokim kontraście
Widoczność obrazu
Odstępy między literami
Wysokość linii
Wyróżnienie Linku
Kolor tekstu